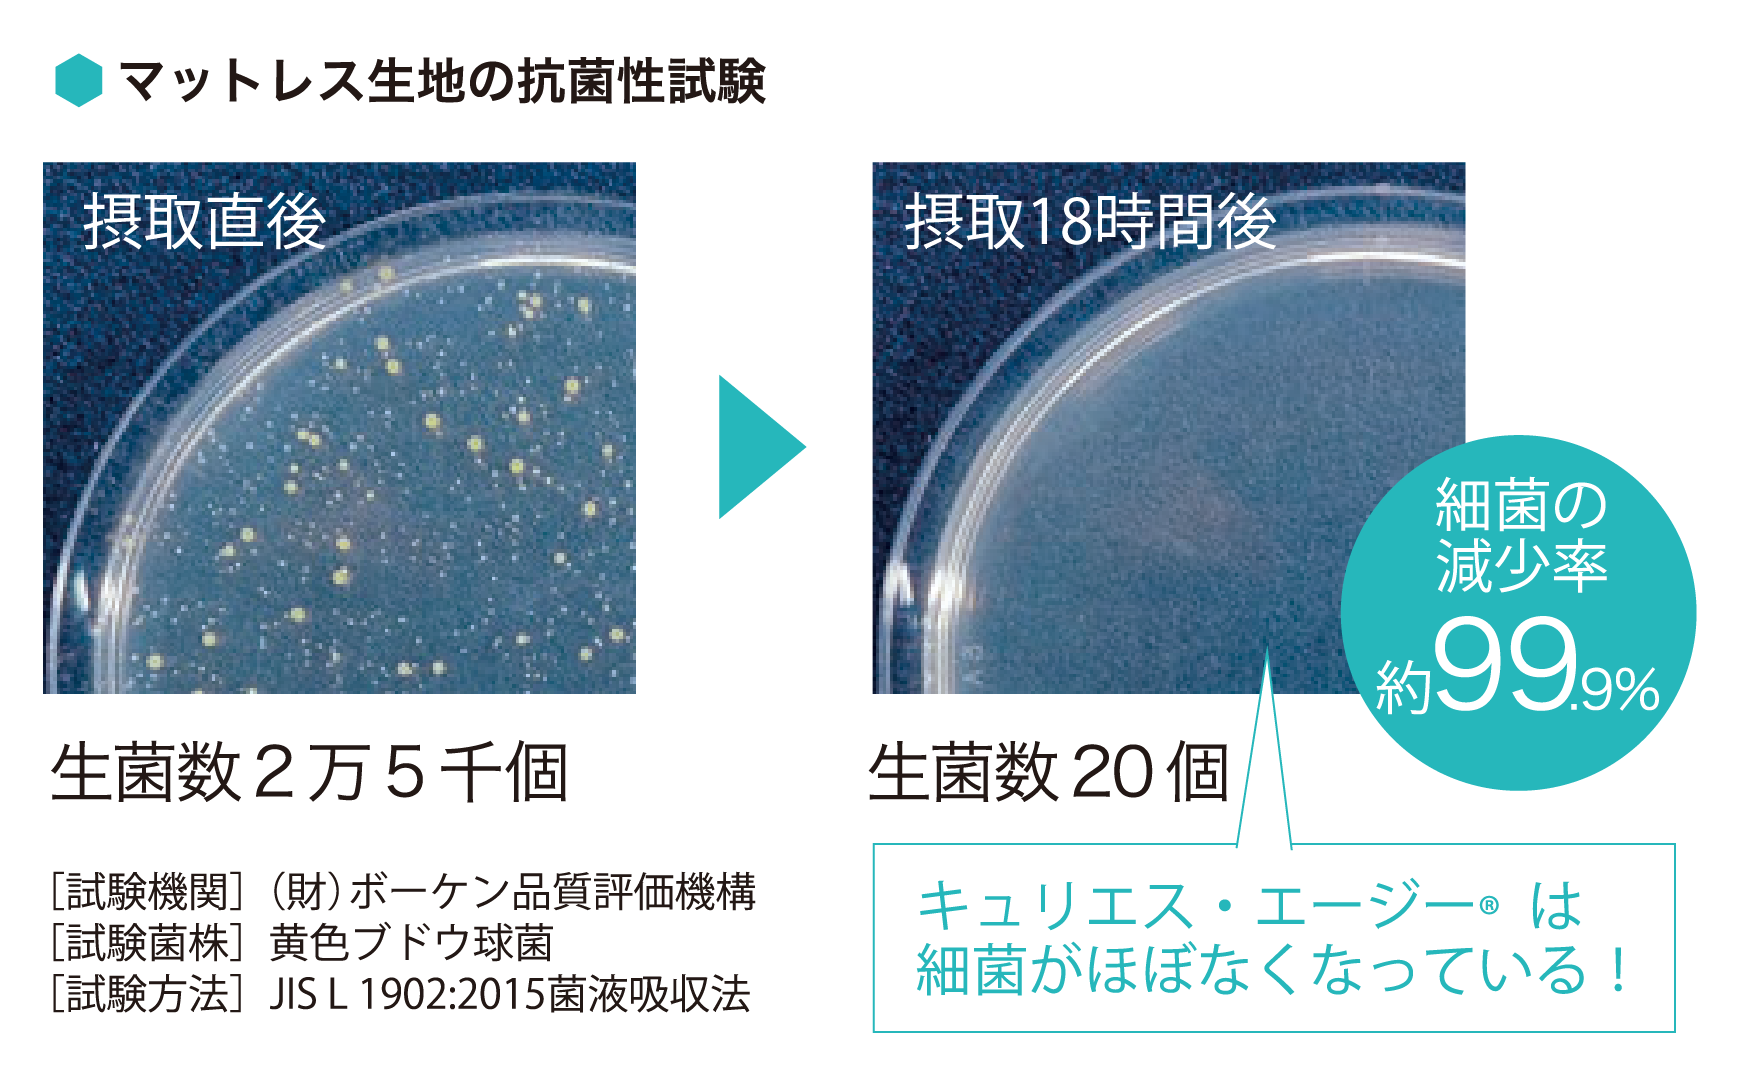

ファニチャードーム スタッフの中でいちばんの腰痛持ち、腰痛歴25年の秋元です。腰痛のことなら様々な経験談延々と「語れます」。「ガラスの腰」と言われながらも登山、トレイルランニングやってます。そんな私ですがここ2年で目に見えて、最悪の状態を脱することができました。それを可能した、「2つのこと」について本コラムでお伝えさせていただこうと思います。
インナーマッスルが死んでいる!?
![]() |
![]() |
|
![]() |
![]() |
今からおよそ3年前。その時までは1年に最低1回は1週間腰痛で動けないことがあり仕事を休まざるを得ないことがありました。登山や軽いランニングも定期的にしていたし太り気味でもないので、ストレッチや針治療や整形外科リハビリでなんとか改善できないかと色々試してきましたが結果はイマイチでした。今思えばゼロ回答で動けるようになるには時間薬しかありませんでした。あるとき、尊敬するラン仲間から名古屋市内のスポーツ整体「コンディショニングサロン」のことを聞き施術6回コースを申し込みました。簡単にいうと「手足指先から顔頭の「こわばり」、体全体の前と後ろの「こわばり」を徐々に緩める施術」を、最低でも60分x6回必要、とのことでした。1回目の施術の診断は、私の体の奥底は「鉄板(てっぱん)」のように凝り固まっていて、その固まった奥底=「インナーマッスル」がカッチカチに硬く、ちょっとした動きで直ぐに「〜痛」というものを発症してしまう体というものでした。
痛みなく健やかに一日過ごすには
私のたどり着いた大切な「2つのこと」
- 体を整えること
自分ではどうすることもできない体の奥底の動かないインナーマッスルを、そして体の動きにとって非常に重要だが凝り固まってしまった「ファシア」「筋膜」を、専門家の施術により「緩めて」生き返らせてもらう。そのあと自分自身で、ストレッチや運動で、時間をかけて、関節の可動域を広げ、筋力をつけていくことが非常に大切。 - 寝る/座る を正しく考える
体をリラックスさせ休ませられるのは、眠る時と座る時。その寝姿勢と座り姿勢は非常に重要。特に就寝中(無意識)の寝姿勢には、ベッドマットレス選びが極めて重要なポイント。
眠ることについては、快眠できない、体が痛くて辛い、など悩みが尽きないですよね。本当はそんなこと考えることなくストレスフリーで朝起きて、エネルギー満タンで一日スタートしたいですよね。
正しいマットレス選びの重要性
- 睡眠の質と疲労回復: 身体に合ったマットレスは、筋肉の緊張を和らげ、深く快適な眠り誘います。
- 腰痛・肩こりの予防と軽減: 体圧を均等に分散し、腰や肩への負担を軽減します。
- 健康被害の予防: 硬すぎると血行不良(褥瘡の原因)、柔らかすぎると腰の沈み込みによる負担(腰痛の原因)。
- 寝ることで腰痛や頭痛やいろんな痛みが悪化することが多い。疲れを取りたいのに元も子もないですよね!
ということで、本題のおすすめマットレスのご紹介です。
LIFE TREATMENT
「LTシリーズ」のご紹介
LTシリーズの特長
高密度連続スプリング®仕様で、非常に高い通気性、耐久性、寝返りのしやすさを実現したモデルです。プロ・ウォール®構造で端まで広く使え、除菌機能生地や環境配慮素材を採用、4つのグレード(Lex 1B~4B)で展開されています。
高密度連続スプリング®
- 理想の寝姿勢を保ちやすい

立っているときは重力うけて縮んだ椎間板は、眠るときには解放され伸びます。高密度連続スプリングのマットレスは、カラダを面で支えるから背筋が伸び解放された状態のまま眠れます。カラダの一部が極端に沈み込みまず余計な力を使わずに自然な寝返りとよい姿勢が維持できるのです。表面は柔らかく内部はしっかりの3層構造。表面クッションで腰・背中などカラダを面全体でしっかり支え、マットレス内部で体圧を分散、ソフトでふんわりとした感触を与えることで、カラダに負担をかけず自然な体勢での眠りを実現します。

- 寝返りしやすい

一晩に約20回が一般的とされている寝返り。寝返りにも質があり、寝返りのしやすいマットレスを選ばないと自然な寝返りができずに、逆にカラダが疲れてしまいます。では一体どのようなマットレスがよいのかですが、まずは柔らかすぎず硬すぎないこと。柔らかすぎるとカラダが沈み込み寝返りが打ちにくく、硬すぎると腰、背中、お尻が圧迫され痛みの原因になることがあります。高密度連続スプリング®マットレスならカラダの重い部分を広い面積でしっかりと支えるため、カラダの一部が極端に沈み込みまず余計な力を使わずに自然な寝返りが可能です。

- マットレス内部に湿気を溜めない高通気性
人は眠くなると手足の温度が高くなり、眠りはじめると深部体温(カラダの内部の温度)を下げるために約200ccの汗をかきます。よい眠りのために、眠りはじめにどれだけ深く眠れるかが重要で、高密度連続スプリング®マットレスなら、通気性がよく、汗を速やかに通し、発散させるのでムレ感を感じることがありません。そのため寝つきがよく、よい眠りへと導くことができます。
日本の高温多湿の気候に適した通気性のよい「高密度連続スプリング®マットレス」。内部に湿気をためこまず、いつでも爽やかな寝心地を実現します。また、鋼線の劣化を防ぎスプリングの寿命を守ります。

プロ・ウォール®
さあ寝る時間だ!!寝るには、ベッドに腰掛けてゴロンとしてカラダを伸ばす、という一連の動作があります。腰痛の方は、この一連の動作=「恐怖」。ちょっとでも動きをミスると「激痛」。プロウォールなら腰掛け時/立ち上がり時の沈み込みがなく安定しており安心。

フランスベッドの硬質の特殊ウレタンフォームがマットレスを囲っているため、周囲の沈み込みがなく有効面積が大幅にアップするから端まで広々使えます。寝返りしても落ちにくく、ベッドのサイズが一つ大きくなったような寝心地です。
除菌機能「キュリエス・エージー®」を標準装備
![]() |
![]() |
除菌機能「キュリエス・エージー®」は、銀イオンの力で付着した細菌を直接除菌します。悪臭の原因菌も除菌し、いつも清潔を保ちます。銀イオンによる除菌機能は後加工ではなく繊維自体が有しているため、機能耐久性に優れ、生地が劣化しない限り半永久的に効果が続きます。高温多湿な日本の寝具の衛生面をサポートします。99.9%の除菌で安心を当たり前に!!
お好みに合わせて Lexマットレスは 3タイプ
ファニチャードーム では、寝心地、ご予算に合わせて3タイプ(硬さはそれぞれソフト/ハードの2種類)を取り揃えております。

- エントリーモデル-1
Lexシリーズ全モデルの共通ベーススペックを備えた基本モデルです。
モデル1〜3の違い
マットレス厚み:26cm
詰め物:ウレタンフォーム使用、ソフトウレタンフォームは1層
- しっとりフィット感を実現したモデル-2
Lexシリーズ全モデルの共通ベーススペックに高触感フォームを採用しフィット感ある寝心地のモデルです。
モデル1〜3の違い
マットレス厚み:28cm
詰め物:高触感ウレタンフォーム使用、ソフトウレタンフォームは2層

- さらに上質な寝心地を追求したモデル-3
Lexシリーズ全モデルの共通ベーススペックに高触感フォーム&ソフトラテックスフォームを採用し、さらに上質なフィット感を実現したモデルです。
モデル1〜3の違い
マットレス厚み:30cm
詰め物:高触感ウレタンフォーム使用、ソフトウレタンフォーム1層&ソフトラテックスフォーム1層

LTシリーズの良いところ一言で
通気性がとても良いから夏場や暑がりの方にはうってつけ!しっかりカラダを支えるためベースは硬めだけど僅かに跳ねるような寝心地もありそれが好きな方にはドハマリ!!一般的な良いマットレスとも一線を画した「オリジナルな寝心地」を感じられます。

まとめ
![]() |
ストレスフリーの快適な体づくりは、一人で解決することはできません。整体/コンディショニングサロンも、自身でのストレッチ/運動も、マットレス選びも、お金と時間と継続性が必要となります。どうにもならないカラダをなんとかしたいと思い立った時に、ぜひ本コラムの内容を実践してみて下さいませ。